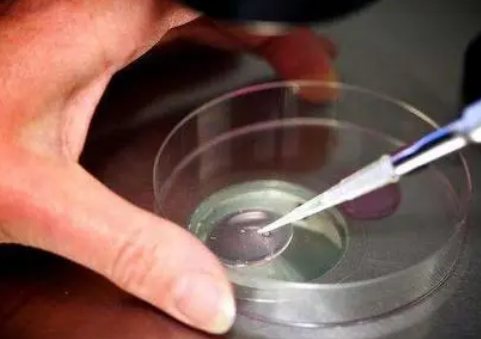

广州作为一座繁华的国际都市,拥有众多顶尖医疗机构,其中也包括提供优质三代试管婴儿服务的公立医院。 对于备孕 couples来说,择合适的公立医院是至关重要的一步,不仅能够获得专业、安全的辅助生殖技术服务,也能最大程度地降低心理压力和经济负担。本文将为您详细介绍广州一些知名的公立试管婴儿医院,并阐述三代试管婴儿的全部流程及费用情况,帮助您做出明智的择。
为了更好地满足不同 couples 的需求,广州市拥有多种类型的三代试管婴儿技术服务。其中,三代试管婴儿主要针对染色体异常、遗传疾病等问题提供解决方案。与传统辅助生殖技术相比,三代试管婴儿在胚胎筛方面更为精准,能够有效降低遗传病的风险,为家庭带来健康的宝宝。
在广州市,不少公立医院都提供优质的三代试管婴儿服务,例如:广州医学院附属第二医院、广州妇孩子童医疗中心等。这些医院拥有一支经验丰富的专业团队,配备先进的辅助生殖技术设备,为患者提供安全可靠的治疗方案。
三代试管婴儿全流程一般包括以下几个步骤:
三代试管婴儿的费用通常在89,543 元左右。
具体费用根据不同的医疗项目、医院等级、个人体质等因素而有所差异。一般来说,主要包含以下几个部分:
试管移植过程通常分为以下几个步骤:将经过筛的胚胎放入女性子宫内,术后需进行一定的休息和观察。 为了提高移植成功率,医生会根据患者的身体状况和胚胎质量择合适的移植方案。
广州市公立试管婴儿医院数量众多,技术水平较高,为想要生育的 couples 提供了多种择。在择医院时,建议结合自身情况,咨询专业医生意见,并详细了解相关费用和流程,最终做出最适合自己的决定。
